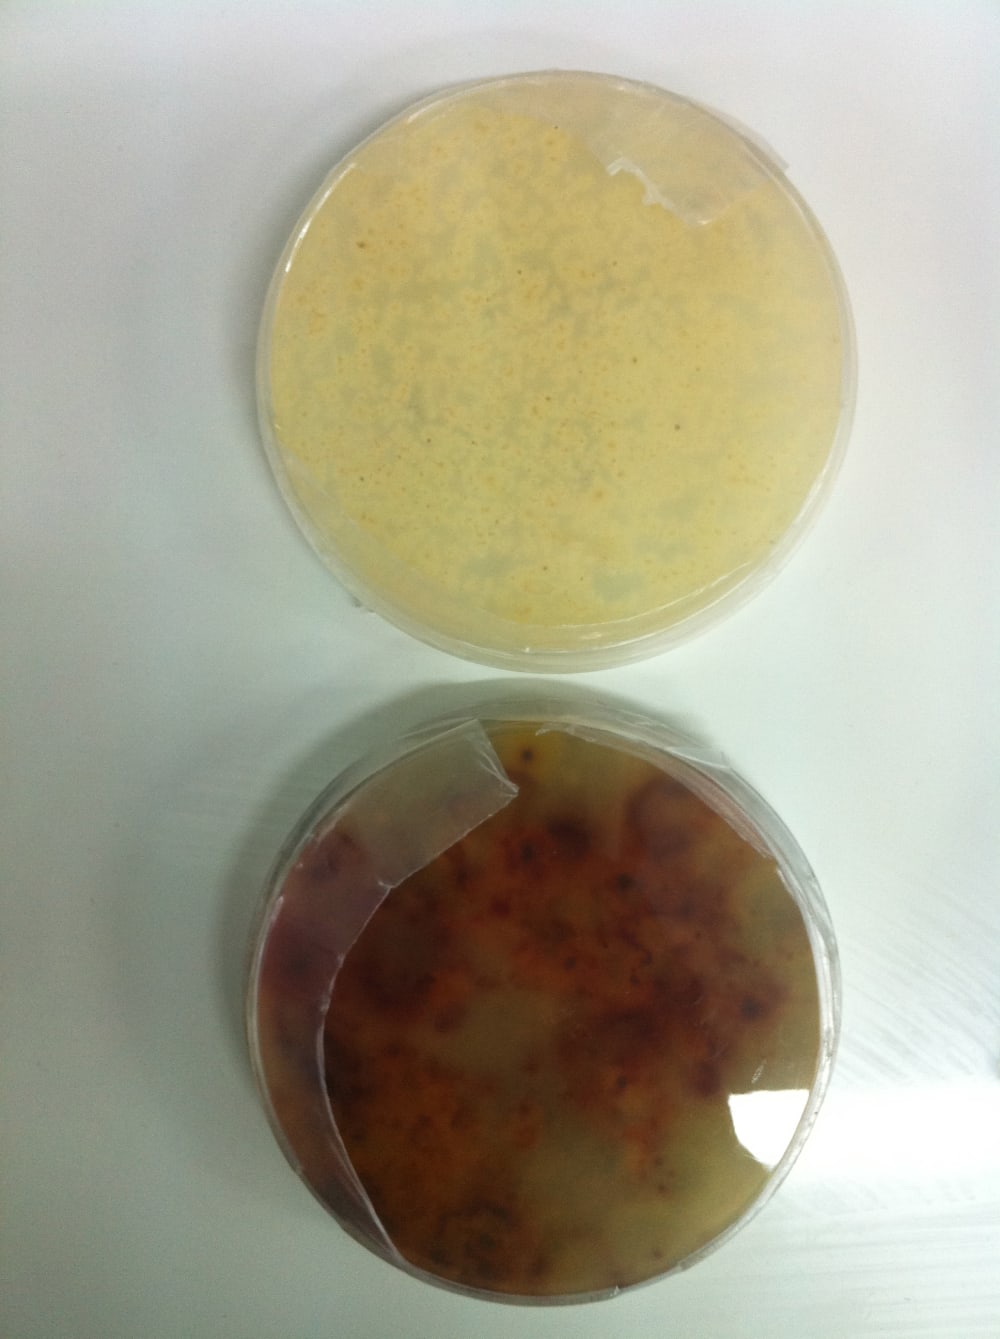

In the last decade organic crops are gaining momentum in international markets due to increased public awareness about the harmful effects that common pesticides have on the human body and the environment. These crops have to deal in new and innovative ways with the different kinds of insects and microorganisms that attack them, for example, using some microorganisms that cause death if eaten by that said insect.
Our enterprise is developing a commercial solution (patent pending) made from extracts of different kind of nuts that can prevent a wide spectrum of fungi from growing on the applied surfaces. The attached images show the effectiveness of the product in its testing stage. Bottom image shows normal fungi growth on a PDA agar (red circles), top image shows no growth whatsoever on the agar due to addition of our product.
The product will be sold to local farmers and vineyard managers as part of a solution to produce organic crops/wine.
Like this entry?
-
About the Entrant
- Name:Leonardo Stari
- Type of entry:teamTeam members:Leonardo Stari
Gustavo Gonzalez - Patent status:pending